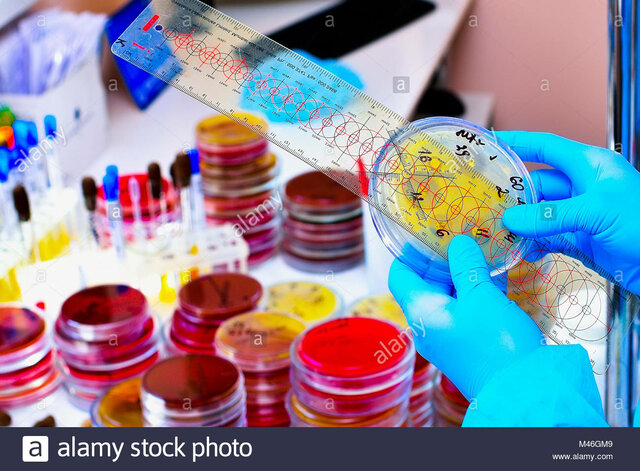
Lazaro Spallanzani

-
Domínguez Flores Ninfa Atzin C18091311
Jacquez Badillo Francisco Emmanuel 18090451
Millán Ortiz Yesenia 18090473
Morales Zárate Jesús Ismael 18090474 -
Observación de celdas y el nombramiento a la "célula".
-
Debate de la generación espontánea.
-
Primeros avances en la medicina a través de la microbiología (1680 a 1940)
-
 Descubrimiento de microorganismos.
Descubrimiento de microorganismos. -
Experimentación con caldos para estudiar el crecimiento microbiano.
-
Realizó un experimento de caldos calentándolos, y no hubo aparición microbiana.
Realizó un experimento de caldos calentándolos, y no hubo aparición microbiana. -
Vacunación contra la viruela.
-
Descubrimiento de microorganismos existentes en el aire y responsabilidad en la fermentación.
-
Principios antisépticos en cirugía.
-
 Descubrimiento del ADN.
Descubrimiento del ADN. -
Vacunación contra la rabia.
-
Descubrimiento de la penicilina.
-
Hubo mayores avances a través de diagnósticos relacionados con la genética (1941 a 1985).
-
Estructura del ADN.
-
Descubrimiento del código genético.
-
Descubrimiento del VIH, la causa de SIDA.
-
 La rama de la medicina más avanzada, detectando a nivel molecular las enfermedades genéticas (1986 a la actualidad).
La rama de la medicina más avanzada, detectando a nivel molecular las enfermedades genéticas (1986 a la actualidad). -
 Se completa la secuencia del primer genoma humano.
Se completa la secuencia del primer genoma humano. -
 Desarrollo de vacuna contra COVID 19 en plena pandemia.
Desarrollo de vacuna contra COVID 19 en plena pandemia. -
Vacunación masiva de la población a nivel mundial
Looking for a timeline maker?
Create timelines for projects, roadmaps, history, lessons, legal cases, and stories with Timetoast. Timetoast is a timeline maker for work, school, research, and stories.













